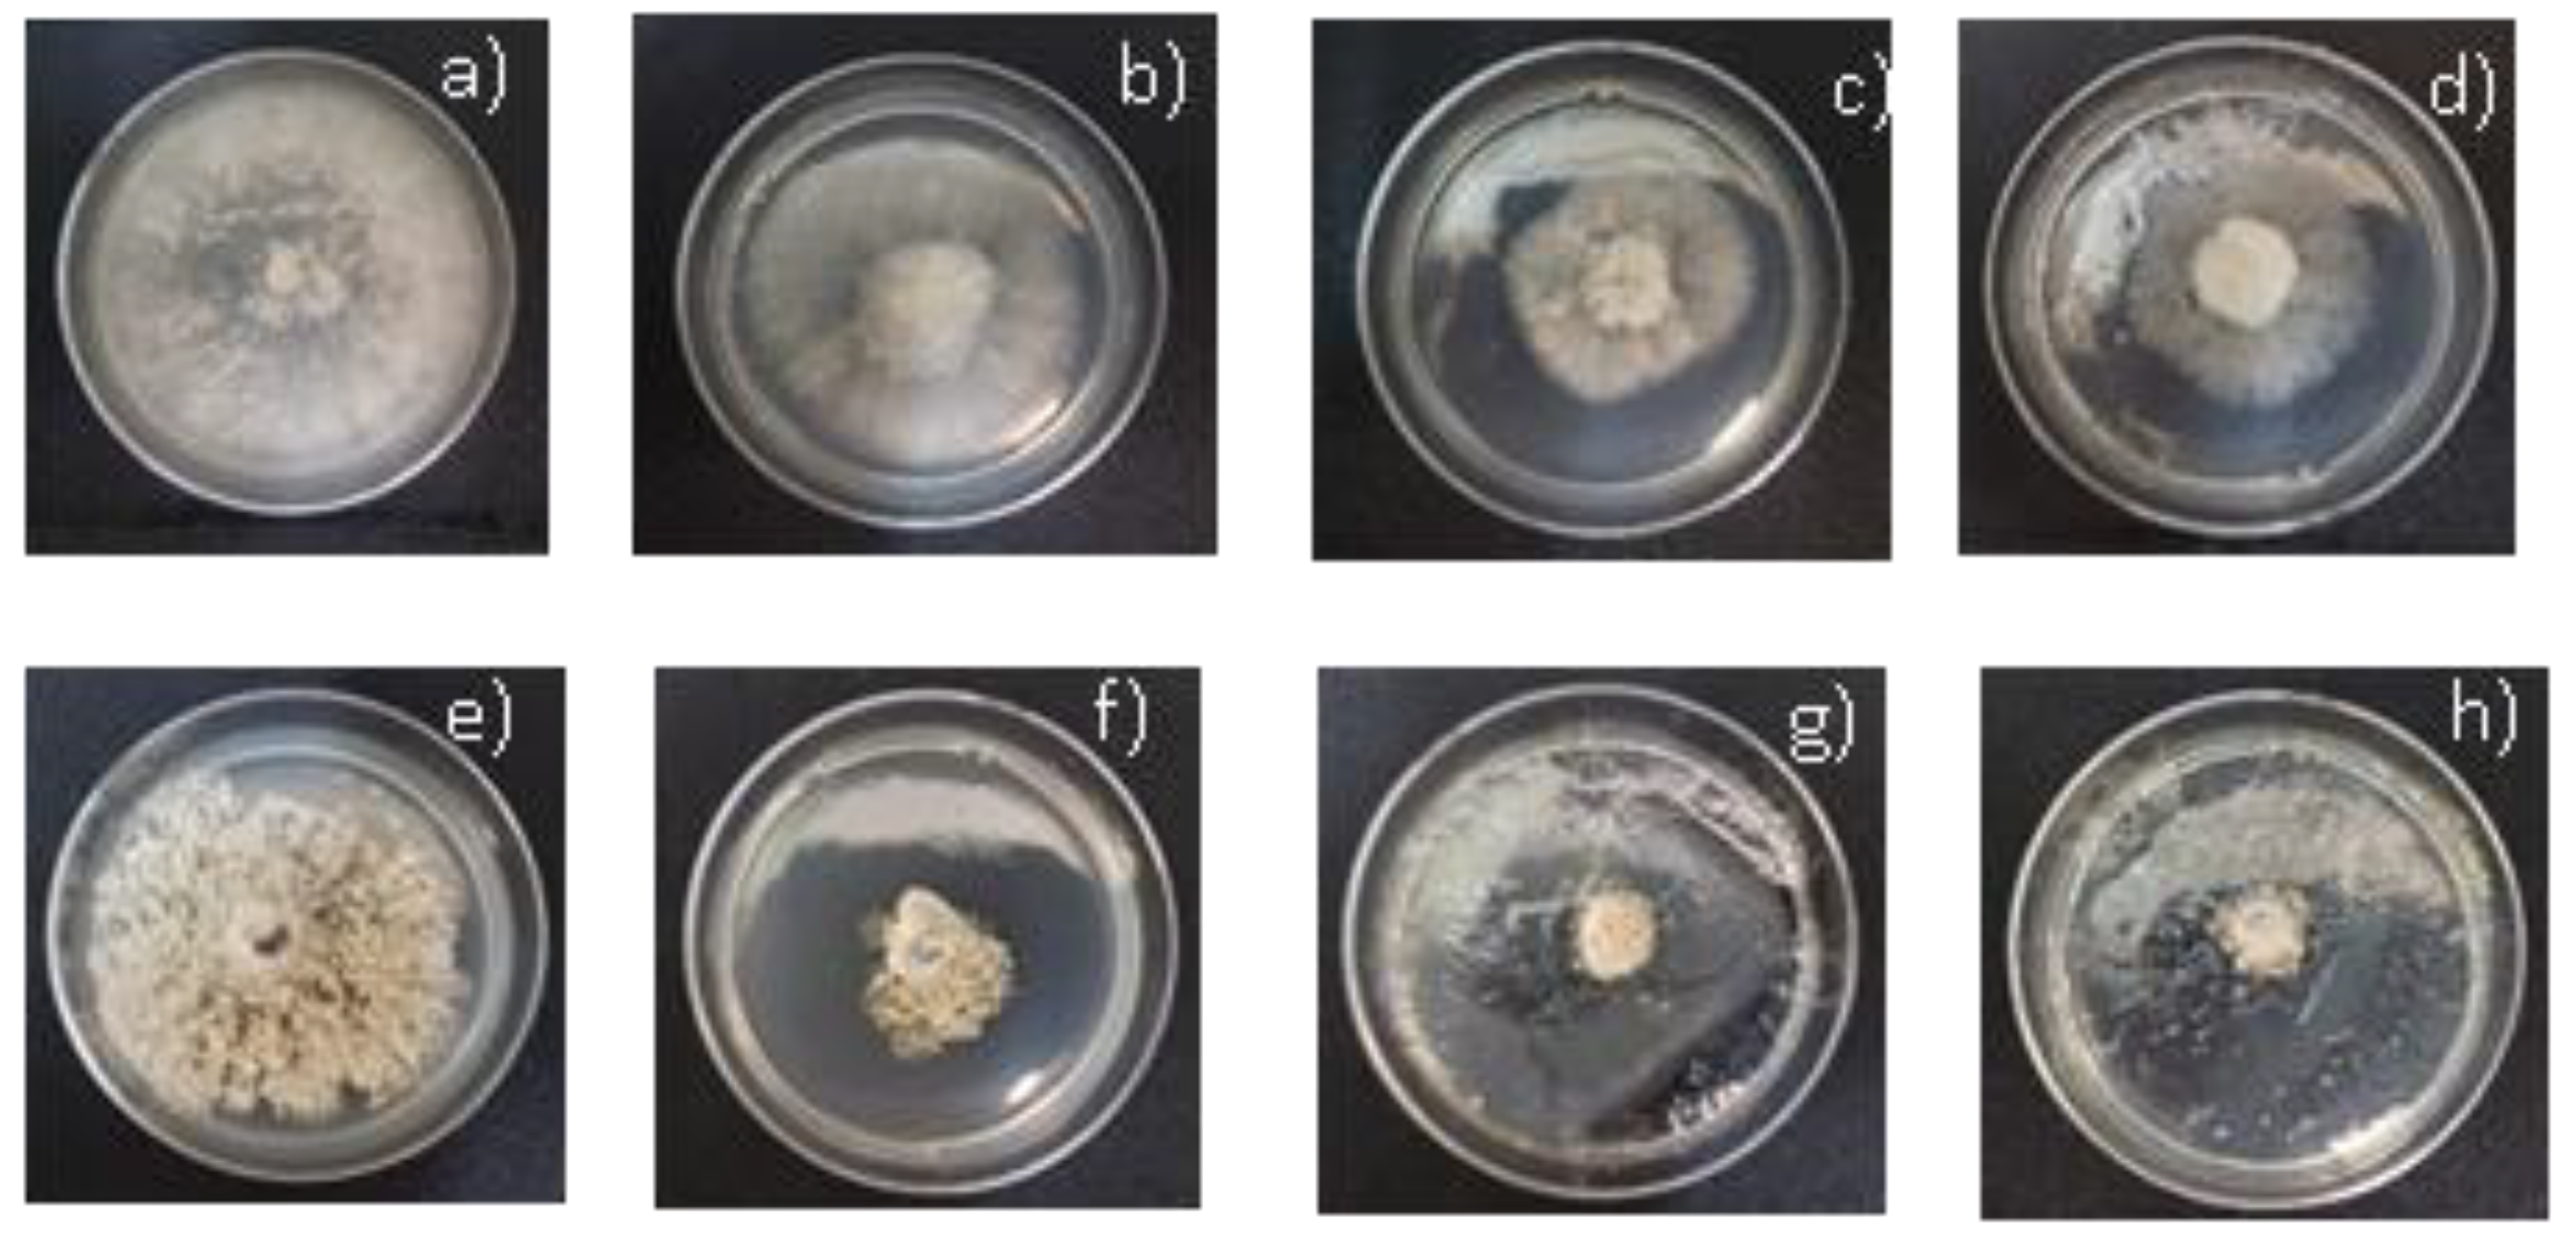
Agronomy 10 00254 g002

Antifungal Activity of Essential Oil and Main Components from Mentha pulegium Growing Wild on the Chilean Central Coast
Abstract
1. Introduction
2. Materials and Methods
2.1. Chemicals
2.2. Plant Material
2.3. EO Extraction and Analysis
2.4. In Vitro Antifungal Activity of the EO and Main Compounds against Phytopathogenic Fungi
2.4.1. Fungal Isolates
2.4.2. In vitro Antifungal Activity
2.5. Statistical Analysis
3. Results and Discussion
3.1. Essential Oil Composition
3.2. In Vitro Antifungal Activity of the EO and Main Compounds on Mycelium Growth of Botrytis cinerea and Monilinia fructicola
4. Conclusions
Supplementary Materials
Author Contributions
Funding
Acknowledgments
Conflicts of Interest
References
- Chandrasekaran, M.; Thangavelu, B.; Chun, S.C.; Sathiyabama, M. Proteases from phytopathogenic fungi and their importance in phytopathogenicity. J. Gen. Plant Pathol. 2016, 82, 233–239. [Google Scholar] [CrossRef]
- Doehlemann, G.; Ökmen, B.; Zhu, W.; Sharon, A. Plant Pathogenic Fungi. Microbiol. Spectr. 2017, 5, 703–726. [Google Scholar]
- Laluk, K.; Mengiste, T. Necrotroph Attacks on Plants: Wanton Destruction or Covert Extortion? Arab. Book 2010, 8, e0136. [Google Scholar] [CrossRef]
- Boddy, L. Pathogens of Autotrophs. In the Fungi, 3rd ed.; Watkinson, S., Boddy, L., Money, N., Eds.; Elsevier Ltd.: London, UK, 2016; Volume 3, pp. 245–291. [Google Scholar]
- Hrustić, J.; Mihajlovic, M.; Grahovac, M.; Delibašić, G.; Bulajic, A.; Krstic, B.; Tanović, B. Genus Monilinia on pome and stone fruit species. Pestic. Fitomedicina 2012, 27, 283–297. [Google Scholar] [CrossRef]
- The Future of Food and Agriculture—Trends and Challenges; FAO: Rome, Italy, 2017; Available online: http://www.fao.org/3/a-i6583e.pdf (accessed on 22 November 2019).
- El Ouadi, Y.; Manssouri, M.; Bouyanzer, A.; Majidi, L.; Bendaif, H.; Elmsellem, H.; Shari-ati, M.A.; Melhaoui, A.; Hammouti, B. Essential oil composition and antifungal activity of Melissa officinalis originating from north-Est Morocco, against postharvest phytopatho-genic fungi in apples. Microb. Pathog. 2017, 107, 321–326. [Google Scholar] [CrossRef] [PubMed]
- Stengele, M.; Stahl-Biskup, E. Seasonal variation of the essential oil of european pennyroyal (Mentha pulegium L.). Acta Hortic. 1993, 344, 41–51. [Google Scholar] [CrossRef]
- Minsal. MHT: Medicamentos Herbarios Tradicionales: 103 Especies Vegetales. Santi-ago, Chile. 2009. Available online: https://www.minsal.cl/wp-content/uploads/2018/02/Libro-MHT-2010.pdf (accessed on 22 November 2019).
- Abdelli, M.; Moghrani, H.; Aboun, A.; Maachi, R. Algerian Mentha pulegium L. leaves es-sential oil: Chemical composition, antimicrobial, insecticidal and antioxidant activities. Ind. Crop Prod. 2016, 94, 197–205. [Google Scholar] [CrossRef]
- Teixeira, B.; Marques, A.; Ramos, C.; Batista, I.; Serrano, C.; Matos, O.; Neng, N.R.; Nogueira, J.M.; Saraiva, J.A.; Nunes, M.L. European pennyroyal (Mentha pulegium) from Portugal: Chemical composition of essential oil and antioxidant and antimicrobial properties of extracts and essential oil. Ind. Crop. Prod. 2012, 36, 81–87. [Google Scholar] [CrossRef]
- Tapondjou, L.A.; Adler, C.; Bouda, H.; Fontem, D.A. Efficacy of powder and essential oil from Chenopodium ambrosioides leaves as post-harvest grain protectants against six-stored product beetles. J. Stored Prod. Res. 2002, 38, 395–402. [Google Scholar] [CrossRef]
- Stoyanova, A.; Georgiev, E.; Kula, J.; Majda, T. Chemical Composition of the Essential Oil of Mentha pulegium L. from Bulgaria. J. Essent. Oil Res. 2005, 17, 475–476. [Google Scholar] [CrossRef]
- El-Ghorab, A.H. The Chemical Composition of the Mentha pulegium L. Essential Oil from Egypt and its Antioxidant Activity. J. Essent. Oil Bear. Plants 2006, 9, 183–195. [Google Scholar] [CrossRef]
- Adams, R.P. Identification of Essential Oil Components by Gas Chromatography/Mass Spectrometry, 4th ed.; Allured Publishing Corporation: Carol Steam, IL, USA, 2007. [Google Scholar]
- Mellado, M.; Espinoza, L.; Madrid, A.; Mella, J.; Chávez-Weisser, E.; Diaz, K.; Cuellar, M. Design, synthesis, antifungal activity, and structure-activity relationship studies of chalcones and hybrid dihydrochromane-chalcones. Mol. Divers. 2019, 1–13. [Google Scholar] [CrossRef]
- Olea, A.F.; Espinoza, L.; Sedan, C.; Thomas, M.; Martínez, R.; Mellado, M.; Carrasco, H.; Díaz, K. Synthesis and In Vitro Growth Inhibition of 2-Allylphenol Derivatives Against Phythopthora cinnamomi Rands. Molecules 2019, 24, 4196. [Google Scholar] [CrossRef]
- Piras, A.; Porcedda, S.; Falconieri, D.; Maxia, A.; Gonçalves, M.; Cavaleiro, C.; Salgueiro, L. Antifungal activity of essential oil from Mentha spicata L. and Mentha pulegium L. growing wild in Sardinia island (Italy). Nat. Prod. Res. 2019, 1–7. [Google Scholar] [CrossRef]
- Hassanpouraghdam, M.; Akhgari, A.; Aazami, M.; Emarat-Pardaz, J. New menthone type of Mentha pulegium L. volatile oil from northwest Iran. Czech J. Food Sci. 2011, 29, 285–290. [Google Scholar] [CrossRef]
- Bouchra, C.; Achouri, M.; Hassani, L.I.; Hmamouchi, M. Chemical composition and antifungal activity of essential oils of seven Moroccan Labiatae against Botrytis cinerea Pers: Fr. J. Ethnopharmacol. 2003, 89, 165–169. [Google Scholar] [CrossRef]
- Tsao, R.; Zhou, T. Antifungal Activity of Monoterpenoids against Postharvest Pathogens Botrytis cinerea and Monilinia fructicola. J. Essent. Oil Res. 2000, 12, 113–121. [Google Scholar] [CrossRef]
- Rosslenbroich, H.-J.; Stuebler, D. Botrytis cinerea—History of chemical control and novel fungicides for its management. Crop. Prot. 2000, 19, 557–561. [Google Scholar] [CrossRef]
- Angelini, R.M.D.M.; Abate, D.; Rotolo, C.; Gerin, D.; Pollastro, S.; Faretra, F. De novo assembly and comparative transcriptome analysis of Monilinia fructicola, Monilinia laxa and Monilinia fructigena, the causal agents of brown rot on stone fruits. BMC Genom. 2018, 19, 436. [Google Scholar]
- Dambolena, J.; Lopez, A.; Canepa, M.; Theumer, M.; Zygadlo, J.; Rubinstein, H. Inhibitory effect of cyclic terpenes (limonene, menthol, menthone and thymol) on Fusarium verticillioides MRC 826 growth and fumonisin B1 biosynthesis. Toxicon 2008, 51, 37–44. [Google Scholar] [CrossRef]
- Luna, E.C.; Luna, I.S.; Scotti, L.; Monteiro, A.F.M.; Scotti, M.T.; De Moura, R.O.; De Araújo, R.S.A.; Monteiro, K.L.C.; De Aquino, T.M.; Ribeiro, F.F.; et al. Active Essential Oils and Their Components in Use against Neglected Diseases and Arboviruses. Oxidative Med. Cell. Longev. 2019, 2019, 1–52. [Google Scholar] [CrossRef] [PubMed]
- Griffin, S.G.; Markham, J.L.; Leach, D.N. An Agar Dilution Method for the Determination of the Minimum Inhibitory Concentration of Essential Oils. J. Essent. Oil Res. 2000, 12, 249–255. [Google Scholar] [CrossRef]

| No. | Chemical Group | Main Components | % Area a | RI b | RIref c |
|---|---|---|---|---|---|
| 1 | Terpene | α-Pinene | 0.20 | 940 | 941 |
| 2 | Terpene | β-Pinene | 0.20 | 984 | 985 |
| 3 | Linear alcohol | 3-Octanol | 0.37 | 993 | 993 |
| 4 | Terpenyl alcohol | Isopulegol | 9.75 | 1147 | 1147 |
| 5 | Terpenketone | Menthone | 20.48 | 1153 | 1154 |
| 6 | Terpenyl derivative | Menthofuran | 1.06 | 1159 | 1160 |
| 7 | Terpenyl alcohol | Menthol | 28.79 | 1176 | 1176 |
| 8 | Terpenketone | Isopulegone | 0.30 | 1178 | 1179 |
| 9 | Terpenketone | Pulegone | 29.33 | 1255 | 1257 |
| 10 | Terpenyl derivative | Menthyl acetate | 8.35 | 1283 | 1283 |
| 11 | Terpene | α-Caryophyllene | 0.28 | 1477 | 1472 |
| 12 | Terpene | Caryophyllene oxide | 0.07 | 1613 | 1606 |
| 13 | Unknown compounds | 0.82 |
| B. Cinerea | M. Fructicola | |||
|---|---|---|---|---|
| Treatment | * EC50 (µg/mL) ± ** SD | *** R | * EC50 (µg/mL) ± ** SD | *** R |
| EO | 301.45 ± 1.49 a | 0.9541 | 24.6 ± 1.33 b | 0.8916 |
| Isopulegol | 333.84 ± 2.00 b | 0.9945 | 20.8 ± 1.21 a | 0.8638 |
| Menthone | 444.19 ± 1.57 c | 0.9801 | 53.4 ± 1.36 d | 0.9342 |
| Menthol | 332.15 ± 2.27 b | 0.9984 | 33.4 ± 1.23 c | 0.8800 |
| Pulegone | 496.48 ± 1.40 d | 0.9649 | 69.6 ± 1.36 e | 0.9228 |
| BC-1000® | 238.28 ± 2.04 e | 0.7999 | - | - |
| Mystic® 520 SC | - | - | 2.19 ± 0.75 f | 0.7999 |
© 2020 by the authors. Licensee MDPI, Basel, Switzerland. This article is an open access article distributed under the terms and conditions of the Creative Commons Attribution (CC BY) license (http://creativecommons.org/licenses/by/4.0/).
Share and Cite
Montenegro, I.; Said, B.; Godoy, P.; Besoain, X.; Parra, C.; Díaz, K.; Madrid, A. Antifungal Activity of Essential Oil and Main Components from Mentha pulegium Growing Wild on the Chilean Central Coast. Agronomy 2020, 10, 254. https://doi.org/10.3390/agronomy10020254
Montenegro I, Said B, Godoy P, Besoain X, Parra C, Díaz K, Madrid A. Antifungal Activity of Essential Oil and Main Components from Mentha pulegium Growing Wild on the Chilean Central Coast. Agronomy. 2020; 10(2):254. https://doi.org/10.3390/agronomy10020254
Chicago/Turabian StyleMontenegro, Iván, Bastián Said, Patricio Godoy, Ximena Besoain, Carol Parra, Katy Díaz, and Alejandro Madrid. 2020. "Antifungal Activity of Essential Oil and Main Components from Mentha pulegium Growing Wild on the Chilean Central Coast" Agronomy 10, no. 2: 254. https://doi.org/10.3390/agronomy10020254
APA StyleMontenegro, I., Said, B., Godoy, P., Besoain, X., Parra, C., Díaz, K., & Madrid, A. (2020). Antifungal Activity of Essential Oil and Main Components from Mentha pulegium Growing Wild on the Chilean Central Coast. Agronomy, 10(2), 254. https://doi.org/10.3390/agronomy10020254
